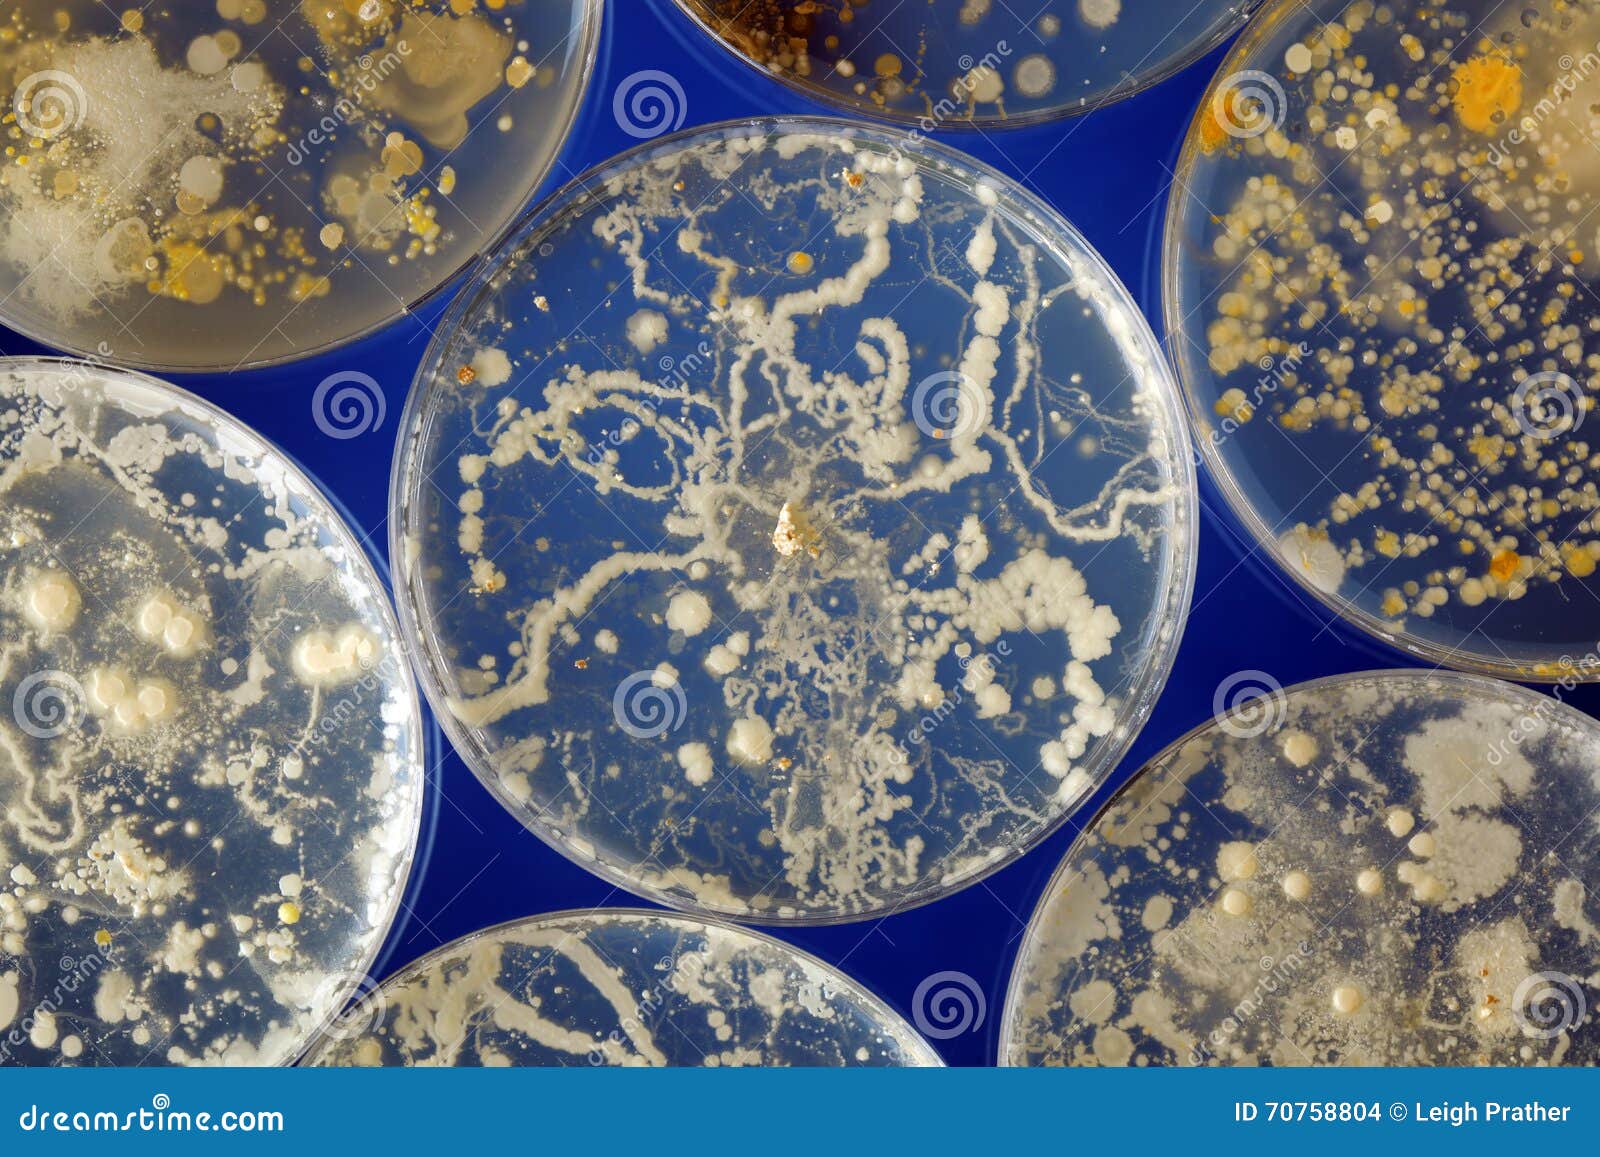

14 ноября 2023 /
0 комментариев
/
25 просмотров
Исследования показывают, что некоторые виды бактерий способны использовать фотосинтез для разложения воды, подобно растениям. Этот процесс, известный как фотолиз воды, имеет потенциал для создания новых технологий в области энергетики и экологии.

1

2
Колония бактерий в чашке Петри на агар-агаре

3
Бактерия Ideonella sakaiensis

4
Ideonella sakaiensis

5
Бактерия Ideonella sakaiensis
.jpg)
6

7
Патогенные микробы в воде

8
Бактерия Ideonella sakaiensis

9
Ruminococcus Albus

10
Rhizobium leguminosarum

11

12
Микроорганизмы обитающие в воде

13

14

15
Ideonella sakaiensis

16

17
Археи метаногены

18

19

20
Полезные микробы

21
Pseudomonas нефть

22

23
Микроорганизмы разлагающие нефть

24

25
Микроорганизмы разлагающие нефть

26

27
Thiomargarita namibiensis

28

29
Thiomargarita namibiensis
30
Псевдомонада aeruginosa

31
Ideonella sakaiensis

32

33
Цианобактерии в архее

34
Plastic Bottle in Ocean

35

36
Микроорганизмы, разлагающие нефтепродукты

37
Пластиковые бутылки в мировом океане

38
Escherichia coli электронная микроскопия

39

40
Ученые и пластик

41
Загрязнение почвы удобрениями

42
Бактерия Pseudomonas aeruginosa

43
Биопленка кандида

44

45
Разложение пластиковой бутылки

46
Колонии бактерий в чашке Петри

47

48
Brevibacillus laterosporus

49
Вода под микроскопом

50
Микроорганизмы-САПРОБИОНТЫ

51

52
Geobacter

53
Микотоксикозы микроскопические грибы

54

55

56
Биоразлагаемый пластик

57
Биопленки микробиология

58
Микроорганизмы в сыре

59

60
Синтетические питательные среды

61
Загрязнение воды эвтрофикация

62
Колонии клеток в чашке Петри

63
Пустыня Атакама помойка

64
Микотоксины Penicillium

65
Сапрофиты актиномицеты

66
Микробиота кишечника

67
Гарднерелла биопленки

68
End Plastic waste

69
Лактобациллус ферментум

70
Грибковые инфекции в чашке Петри

71
Биоразлагаемые бутылки

72

73

74
Бациллы аэробы

75
Saccharomyces cerevisiae колонии

76
Пародонтопатогенные микроорганизмы

77
Легионелла биопленки
:max_bytes(150000):strip_icc()/Trichoderma-4a927bd0b1504296a53f9c71979a101c.jpg)
78
Триходерма Петри

79
Свалка в пустыне Атакама

80

81
Бактерия Escherichia coli

82
Надо ли мыть курицу перед разделкой

83
Бактериофаг вирус бактерий

84

85

86

87

88
Мусороперерабатывающий завод Волхонка

89
Bdellovibrio bacteriovorus

90

91
92
Микропластик в почве

93
Ideonella sakaiensis

94
Горы пластикового мусора
95
Колонии бактерий в чашке Петри

96
Бактерия Ideonella sakaiensis

97
Инфекции в воде

98
Пробирки с микроорганизмами

99

100
Микроорганизмы океана

101

102

103
Загрязнение питьевой воды

104
Биоплёнка легионелла

105

106
Solution to Plastic pollution

107
Биоразлагаемый пластик

108
/imgs/2019/08/05/10/3498344/fd5add9923fc5617704d3ef2e76e63b7fa05c8a3.jpg)
109
Микроорганизмы поглощающие нефть
Роль бактерий в фотолизе воды
Недавние исследования показали, что определенные виды бактерий, такие как цианобактерии, способны проводить фотолиз воды с помощью ферментов, подобных тем, которые присутствуют у растений. Это открытие открывает новые перспективы для использования бактерий в процессах разложения воды и производства чистой энергии.